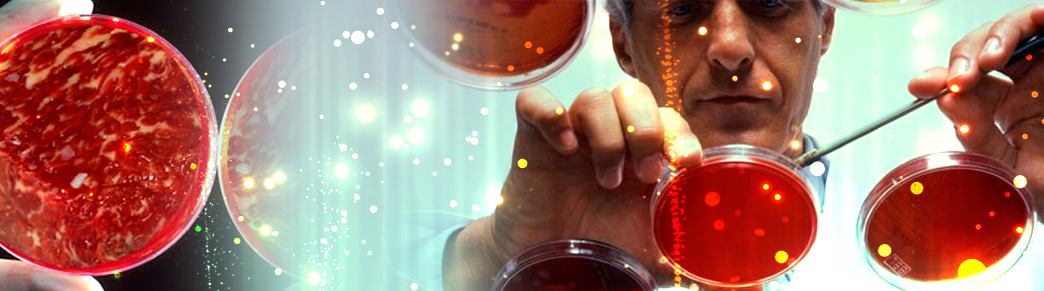
carne-artificial

Células-tronco humanas clonadas pela primeira vez
maio 17, 2013Adolescente de 18 anos cria um super capacitor que recarregue celular em 30 segundos
maio 24, 2013Uma boa notícia para os vegetarianos, cientistas aprenderam a fabricar carne artificial. Recentemente, engenheiros americanos da companhia Modern Meadow fizeram essa declaração sensacional à comunidade científica. Eles apresentaram uma tecnologia ímpar de fabricação de carne artificial.
Na base de todo o processo está a produção de fibras de carne com células do tecido muscular dos animais, obtidas por meio de biópsia. Posteriormente as fibras são prensadas em diferentes formas, e em seguida “cultivadas” em um bioreator. Os elaboradores chamam, em tom de brincadeira, de impressora, o aparelho, que dá a forma inicial crua do bife, e a matéria-prima de bio-tintas, que podem desenhar um futuro feliz do mundo, sem violência contra os animais. Desse modo a companhia Modern Meadow planeja organizar a produção também de peças de couro.
A ideia é magnífica por si só. Pode-se imaginar quantas vidas de animais serão preservadas pelos análogos “artificiais” de carne e couro. Além disso o próprio processo de obtenção de carne em laboratórios é muito mais ecológico do que sua obtenção em granjas pecuárias. É perfeitamente possível que no futuro esse método seja muito mais econômico do que o ciclo total de produção de carne natural, começando com a criação do animal, sua manutenção e alimentação, depois abate, transportes etc.
Segundo dados da FAO, a organização de alimentação e agricultura da ONU, só em 2012 foram abatidos 320 milhões de vacas, 1,4 bilhões de porcos e 55 bilhões de frangos. A companhia Modern Meadow coloca o objetivo de diminuir, ao menos um pouco, estes números. Além disso, em caso de produção de carne e couro artificiais, desapareceria o aspeto ético relacionado com o abate de animais e, consequentemente o número de consumidores em potencial aumentaria consideravelmente, incluindo mesmo os vegetarianos.
Peter Thiel, um dos primeiros investidores do Facebook e fundador do Paypal, segundo alguns dados, investiu neste projeto cerca de 350 mil dólares. Ele é considerado por ser um homem que não joga dinheiro fora e escolhe com muito cuidado os projetos que financia. Por isso, se pode supor que Modern Meadow terá bastante. O espírito combativo da empresa é apoiado também pela organização de defesa dos direitos dos animais PETA (People for the Ethical Treatment of Animals) que propôs um prêmio de um milhão de dólares à primeira empresa que começar a produção em massa de carne de galinha sintética.
Entretanto, não se sabe absolutamente de que modo o consumo de carne artificial se refletirá sobre a saúde das pessoas e se muitos vegetarianos concordarão com tal compromisso. Marina Tsapovich, nutricionista, expressou sua opinião à Voz da Rússia:
“Eu considero que só o tempo e pesquisas minuciosas desse produto poderão dar-lhe carta branca. Ninguém sabe qual será o efeito dessa “carne” sobre nossa saúde dentro de 10-15 anos e também sobre as futuras gerações. Todos nós lembramos muito bem a euforia da humanidade quando foram criados os primeiros produtos geneticamente modificados. Agora fazemos tudo para que essas “obras-primas” do progresso científico não caiam em nossas mesas. A prática mostra que somente produtos naturais são bons para a saúde e nos ajudam a permanecer jovens e fortes. Eu acompanhei com interesse essa elaboração, mas é pouco provável que algum dia recomende a meus pacientes consumir semelhante carne”.
Também o vegetariano praticante Piotr Shekalev, líder do projeto “Alimento para reflexões” é cético em relação à criação de carne artificial.
“Eu pessoalmente considero que isto não tem sentido, porque os que querem renunciar à carne, renunciam à ela sem substitutos e os que estão acostumados à carne encararão a ideia da carne artificial como uma ofensa. Possivelmente, este produto ajudará a alcançar um compromisso nas famílias onde os cônjuges têm pontos de vista diferentes em relação à alimentação, mas não se pode construir um sistema social sobre o compromisso.”.
O tempo mostrará se a carne artificial será uma revolução no sistema da alimentação ou a ideia morrerá na raiz, não tendo repercussão entre os consumidores. Ficamos a aguardar o desenvolvimento dos acontecimentos.
fonte: http://rus.ruvr.ru/

1 Comment
Eu vou comer essa porcaria nada. Se é feito da carne como é que o vegetariano vai comer? meus amigos pensem um pouco.